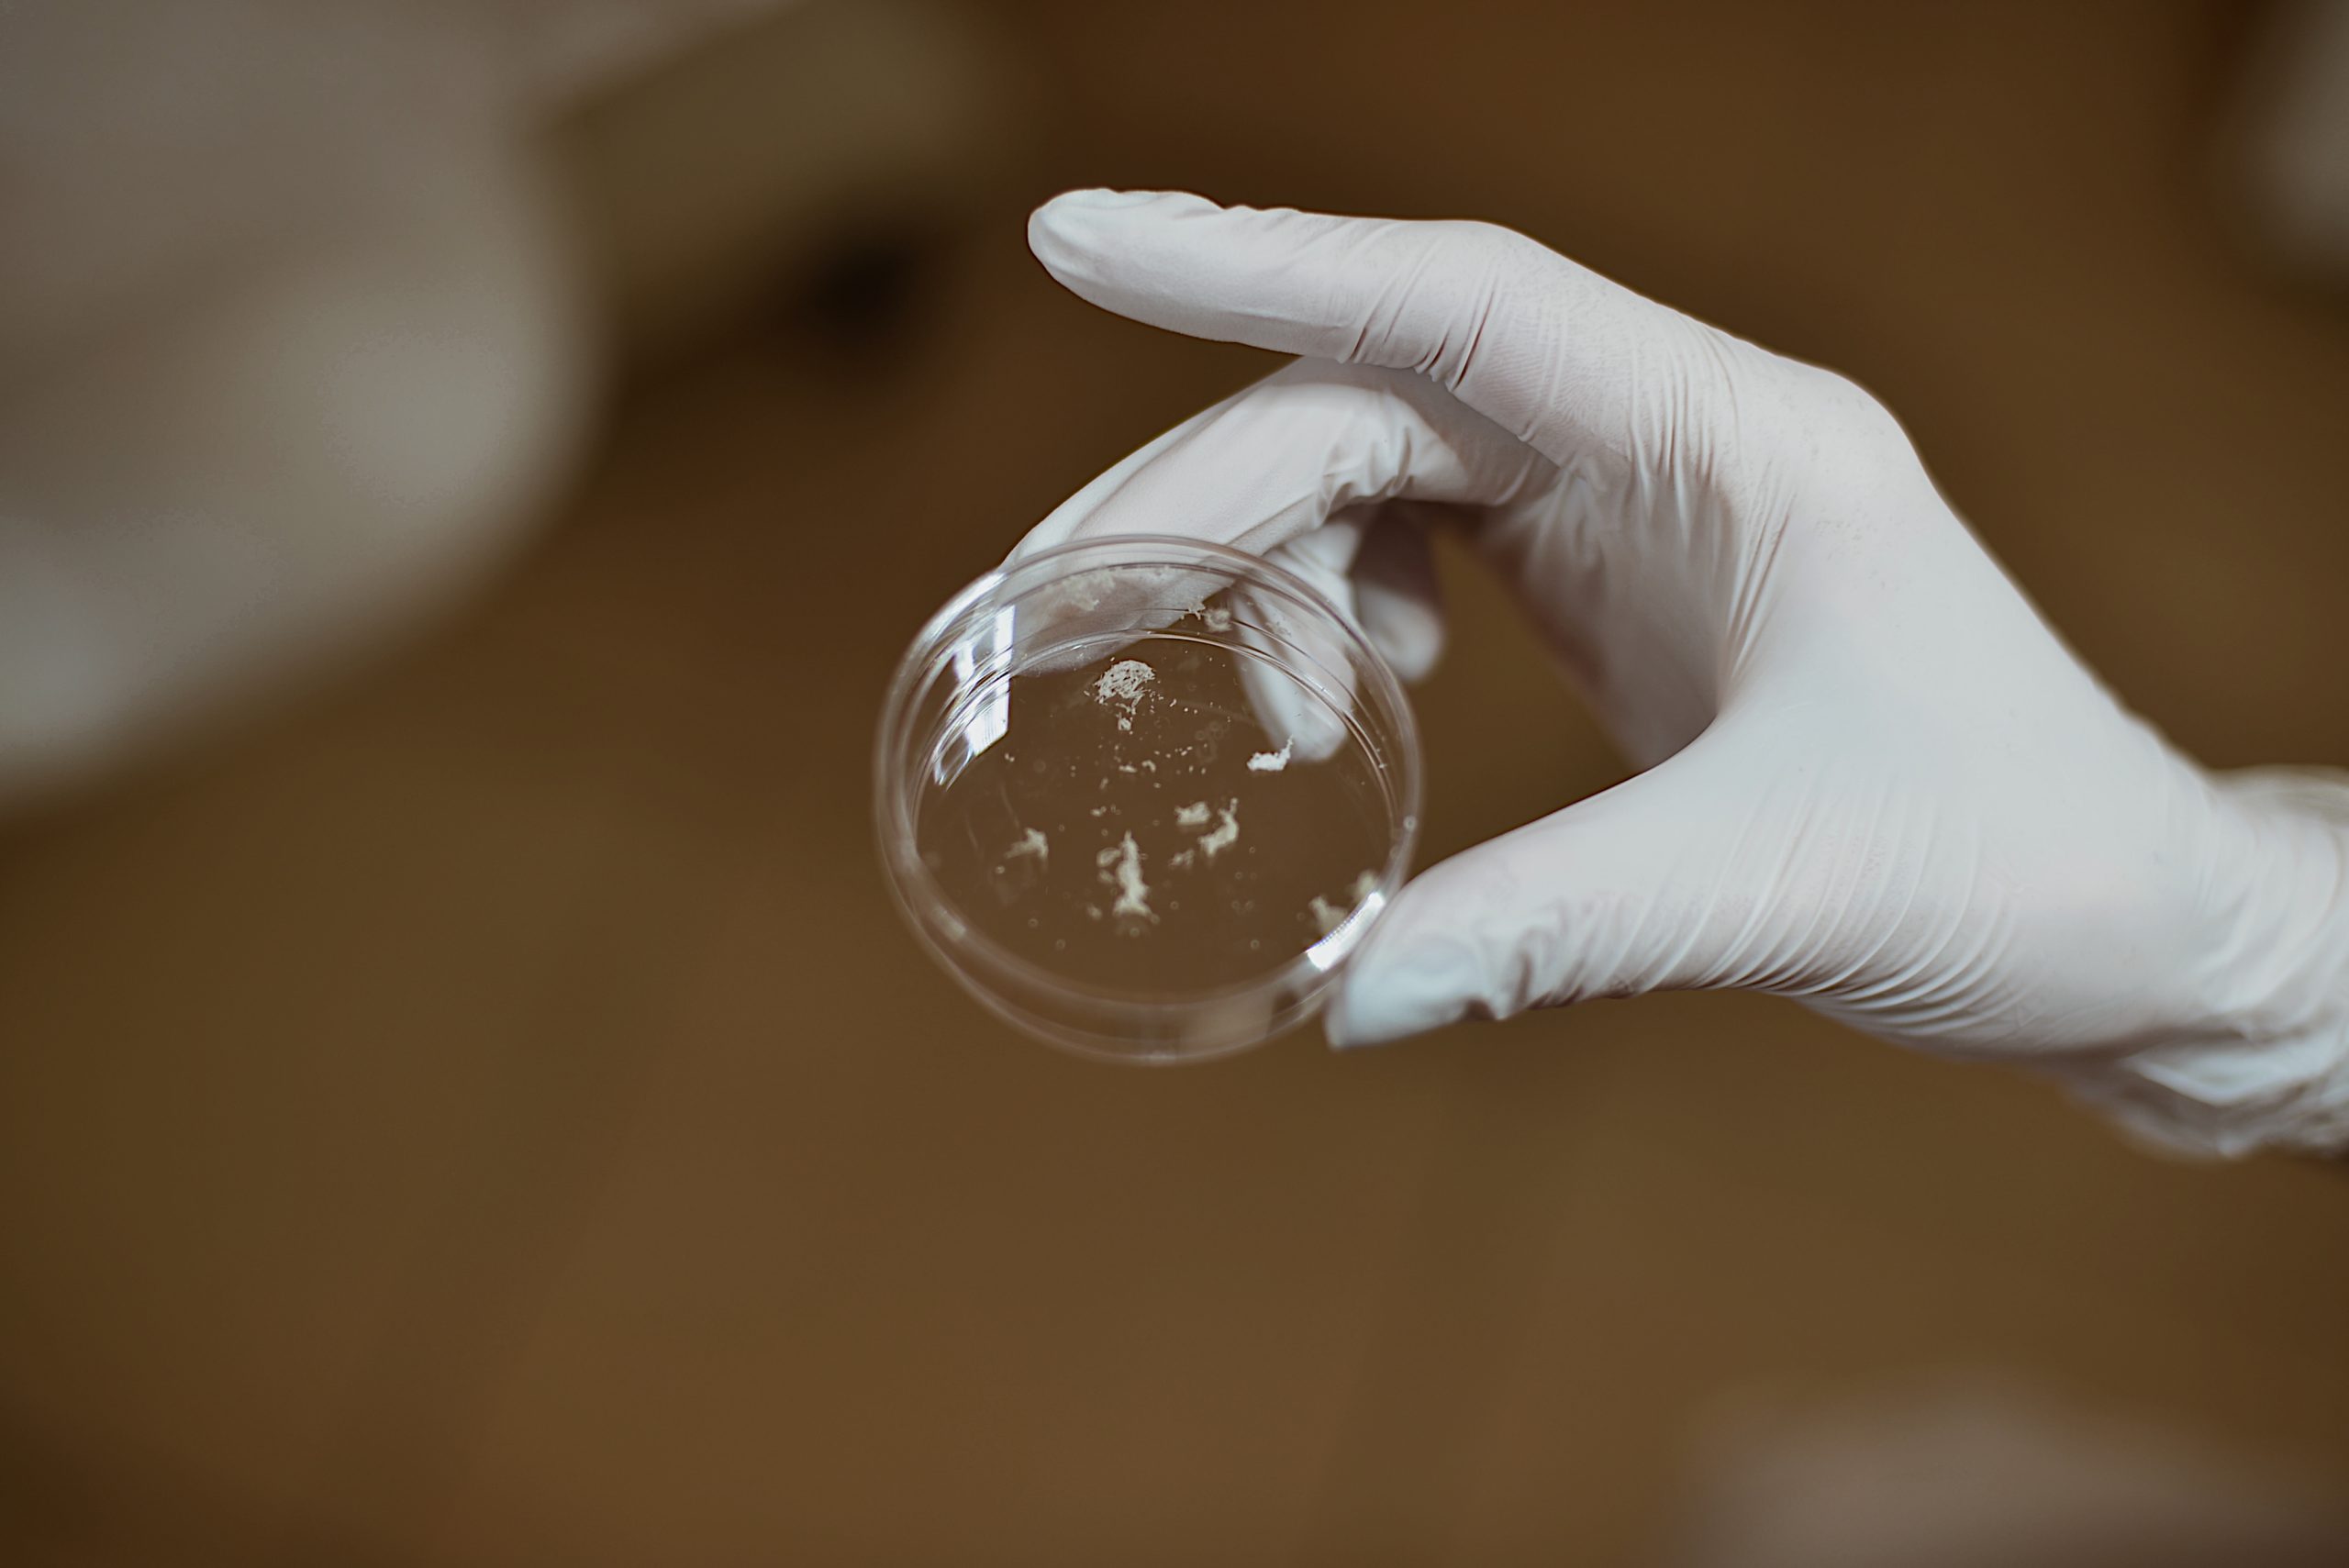
IMG_5384

Profesjonalna diagnostyka
Nasz gabinet współpracuje z laboratorium Dermo-Lab, które przeprowadza diagnostykę infekcji grzybiczych z wykorzystaniem nowoczesnej metody molekularnej, która obejmuje wykorzystanie nowoczesnych technologii do dokładnej i szybkiej diagnostyki. Główną metodą jest PCR (reakcja łańcuchowa polimerazy), która pozwala na wykrycie DNA lub RNA patogenów wywołujących infekcję grzybiczą.
Przygotowanie do badań
w dniu badania – nie myć stóp i niczym nie smarować, w przypadku paznokci dłoni zalecane jest nie smarować ich żadnymi preparatami oraz na około 2-3 godziny przed badaniem nie należy myć dłoni
usunięcie z płytki paznokcia lakieru, odżywek, kremów, sztucznych paznokci – na 24 h przed pobraniem próbki
W przypadku leczenia przeciwgrzybiczego zaleca się odczekanie:
minimum tygodnia – leczenie miejscowe (maści, kremy, lakiery)
minimum trzech miesięcy – leczenie doustne (tabletki) UWAGA ! w praktyce leki doustne kumulują się w płytce paznokcia do pół roku po skończeniu leczenia